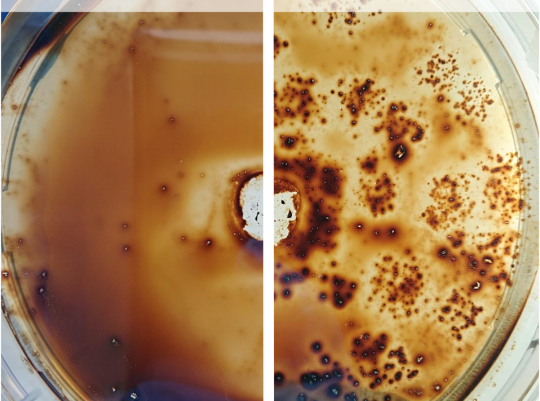

Domina studijos Klaipėdos universitete
Reikalinga akademinė pažyma/diplomo kopija
Negaliu prisijungti prie VMA/AIS ar kitos KU sistemos
Turiu kitą klausimą